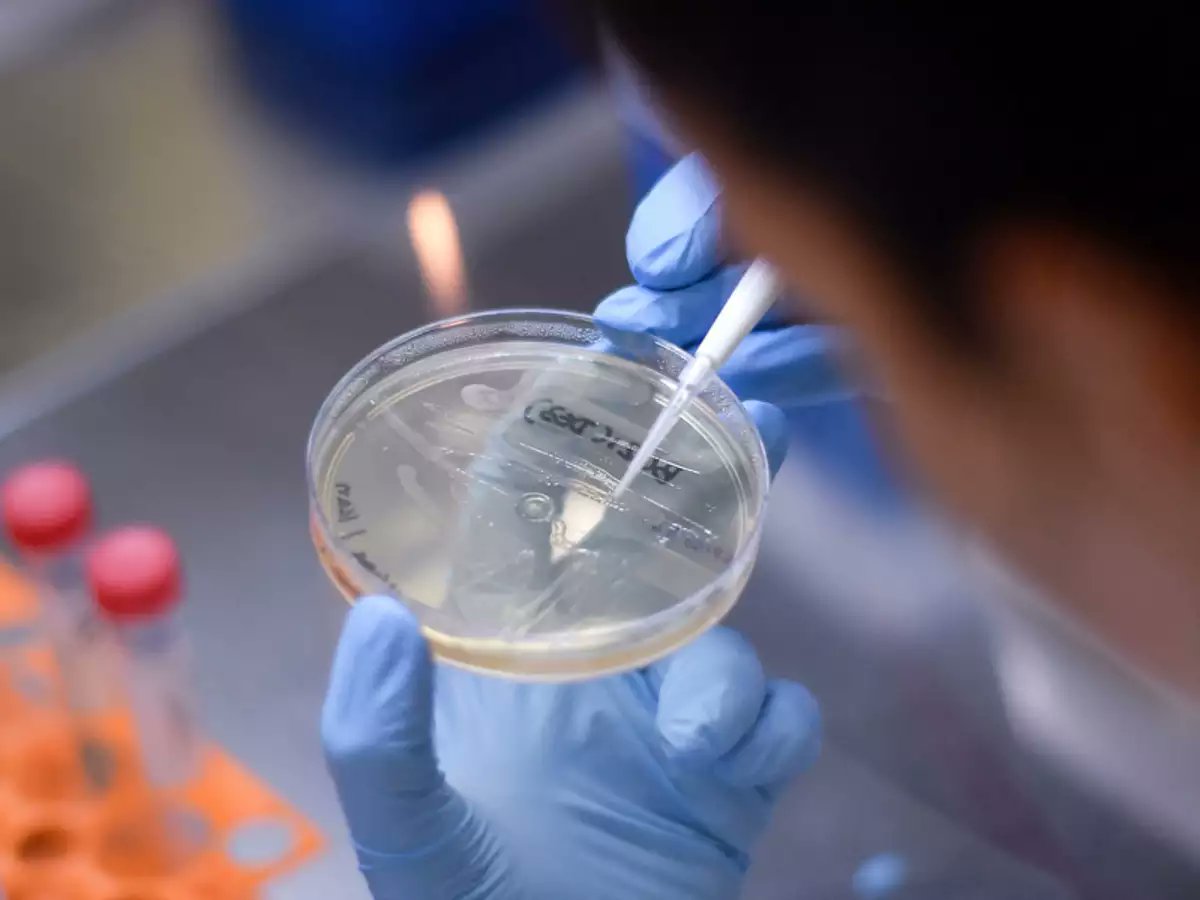

⚡️ “بدء تصنيع لقاح مُحتمل لفيروس كورونا على نطاق واسع”
أعلنت شركة الأدوية «أسترا زينيكا» البريطانية عن بدء تصنيع اللقاح المُحتمل لفيروس كورونا «AZD1222»، أمس الأول الجمعة، والذي طوره علماء جامعة أوكسفورد البريطانية، بعد ثبات فعاليته ضد الفيروس
#بوبساي #العلوم_للعموم #فيروس_كورونا
#بوبساي #العلوم_للعموم #فيروس_كورونا
توصلت الشركة إلى شراكة مع «تحالف ابتكارات التأهب الوبائي» و«التحالف العالمي للقاحات والتحصين» ووقعت اتفاقية تُقدر بـ750 مليون دولار لدعم إنتاج وتوزيع 300 مليون جرعة من اللقاح المُحتمل، على أن تبدأ الشركة بتوزيع الجرعات بحلول سبتمبر المقبل
#بوبساي #العلوم_للعموم #فيروس_كورونا
#بوبساي #العلوم_للعموم #فيروس_كورونا
قالت صحيفة "The Sun" البريطانية إن الأنباء تفيد بأن لقاح #فيروس_كورونا_المستجدّ قد يكون جاهزًا للإعطاء من خلال الاستنشاق بجهاز يشبه أجهزة الربو
#بوبساي #العلوم_للعموم #فيروس_كورونا
#بوبساي #العلوم_للعموم #فيروس_كورونا
أيضاً وقَّعت الشركة اتفاقية مع «معهد سيروم الهندي» لتوصيل مليار جرعة من اللقاح للدول ذات الدخل المحدود والمتوسط وبفضل دعم رجل الأعمال بيل جيتس
#بوبساي #العلوم_للعموم #فيروس_كورونا
#بوبساي #العلوم_للعموم #فيروس_كورونا
كما تدعم الشركة بناء خطوط إنتاج في دول مختلفة حول العالم لضمان وصول اللقاح إلى جميع شعوب العالم
#بوبساي #العلوم_للعموم #فيروس_كورونا
#بوبساي #العلوم_للعموم #فيروس_كورونا
يذكر أن جامعة أوكسفورد أعلنت مؤخراً عن بدء المرحلة السريرية الثانية والثالثة من التجارب على اللقاح المُحتمل مع 10 آلاف متطوع، وذكرت صحيفة «The Sun» البريطانية أن فريق علماء أكسفورد واثقون من نجاح اللقاح بنسبة 80%
#بوبساي #العلوم_للعموم #فيروس_كورونا
#بوبساي #العلوم_للعموم #فيروس_كورونا
لا يوجد حالياً لقاح أو علاج متاح لفيروس كورونا ولكن المختصين والعلماء في جميع أنحاء العالم يختبرون العقاقير الحالية المضادة للفيروسات لمعرفة ما إذا كان بإمكانهم التغلب على #فيروس_كورونا، كما يعملون على إنتاج لقاحات محتملة للفيروس
Loading suggestions...